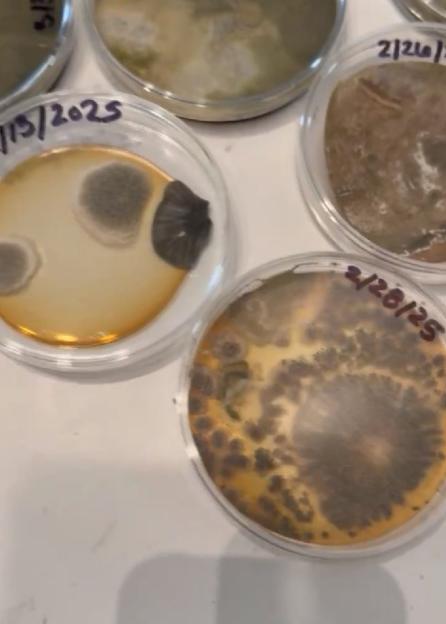
NINTCHDBPICT001059870603

JUST months after moving into her new home, Mercedes Brooke was horrified to find her hair falling out and a rash spreading across her skin.
But it was only when the now 30-year-old’s live-in Labradoodle Berkley starting that she knew something was seriously wrong.
 Mercedes Brooke believes her flat made her sickCredit: Kennedy News
Mercedes Brooke believes her flat made her sickCredit: Kennedy News
 The 30-year-old only realised something was wrong when her dog Berkley started losing his coatCredit: Kennedy News
The 30-year-old only realised something was wrong when her dog Berkley started losing his coatCredit: Kennedy News
Ever since she settled into her one-bedroom rental apartment in Colorado, US, in August 2024, the student, who was 28 at the time, had issues with the unit above her bed, which she claims was leaking water.
She contacted the management company to fix the problem and was assured it had been sorted.
“But it was still leaking water and that went on for about three months. It kept dripping on my face,” Mercedes said.
She told them she was worried that constant water would lead to growing, but they insisted it would not happen.
“I started getting these little bumps on my arms. I thought it was just allergies,” she explained.
She added: “When I washed my hair in the shower, clumps of hair started falling out and I thought it was just the water.
“But then my dog started losing her hair and I knew something was going on.
“Then I started getting these rashes.
“I had lost around 15lbs [in weight] in a month.
“I went home for a week and all the symptoms went away. That’s when I knew it was something to do with the house.”
 Mercedes with a swollen face, which she claims was caused by mouldy flatCredit: Kennedy News
Mercedes with a swollen face, which she claims was caused by mouldy flatCredit: Kennedy News
 The rash she developed a few months after moving inCredit: Kennedy News
The rash she developed a few months after moving inCredit: Kennedy News
 The student lost half her hairCredit: Kennedy News
The student lost half her hairCredit: Kennedy News
Once back at her flat after the week at her parents’ home, Mercedes decided to check the AC unit and claims it was “full of mould”.
She then saw an even more stark deterioration in her health over the next three months.
Mercedes said: “By month three, half of my hair was gone. I went to the hospital multiple times. I was not sleeping at all and crying all the time.
“I was vomiting blood. My menstrual cycle lasted two and a half months. I remember asking the doctor ‘do I have an autoimmune disease or cancer?’
“I got some bloodwork done and told them I had mould in my house. After testing my blood, every single type of mould came back significantly high.
“My doctor and family said if you don’t leave this apartment you’re just going to get worse and worse.”
Over the next few months, Mercedes claims she sent around 300 emails, messages and calls to her landlord and management to address the problem before deciding to end her lease early.
Samples taken from the flat’s air conditioning unitCredit: Kennedy News
Samples taken from the flat’s air conditioning unitCredit: Kennedy News

The student then launched a lawsuit against the property management for living in an uninhabitable environment, which was settled in July last year.
Mercedes has returned back to her full health and is now urging others to always “stand up for themselves”.
She said: “I was told I was dramatic and making everything up. I said to them ‘would you want this to happen to your daughter?’
“They could’ve just replaced the unit – it was completely avoidable. Hopefully now they’ll never do it to another person.
“I felt like [the house] was slowly killing me. I went through running and weight-training every day to such a state of depression.
“My hair’s started growing back, the rashes have gone, I now wake up with energy.
“If you’ve done all the due diligence on your side and still feel completely neglected, absolutely you should stand up for yourself. You have to fight back.”
 Mercedes has returned back to her full healthCredit: Kennedy News
Mercedes has returned back to her full healthCredit: Kennedy News
How mould affects your health
The says the problem with mould is that it produces allergens (substances that can cause an allergic reaction), irritants and, sometimes, toxic substances.
When inhaled or they get into the skin, it causes nasty symptoms.
At first, these toxins may not cause any harm at low levels. But if they are consistently in the air, it starts to cause side effects.
People who live in homes with mould are more likely to have:
- Respiratory problems
- Respiratory infections, including (an infection of the airways with the fungus Aspergillus)
- Allergies
- Asthma, including
- Problems with the immune system
- Mental health issues, from worries about the health impacts of mould to stress over unpleasant living conditions and destruction of property
Responding to the introduction of Awaab’s Law, Simone Miles, chief executive, Allergy UK , said: “Mould and damp can have a severe impact on health, especially for those with respiratory conditions.
“An allergy to mould exacerbates asthma in people who are already affected or can lead to people becoming asthmatic due to the damage it causes to the airways.
“Exposure to indoor dampness and fungal contamination has been associated with as much as a 50 per cent increase in the risk of asthma.
“With no respite at home from symptoms, it is no surprise that seven in 10 people with an indoor allergy say it takes a toll on their mental
wellbeing.”
Jeroen Douwes, a professor of public health at Massey University, wrote in The Conversation : “Prolonged exposure to high levels of indoor dampness can reduce lung function and cause chronic health problems such as asthma.
“Those who already suffer from asthma and allergies are more likely to have more severe symptoms when exposed.”
He added: “People who live in damp and mouldy homes are also at increased risk of which, in turn, may increase the risk of respiratory symptoms and asthma.”
Recent studies have suggested mould exposure could lead to the development of asthma in some children.
And in 2019, the presence of damp and/or mould in English homes was linked to approximately 5,000 cases of asthma and 8,500 lower respiratory infections in children and adults.
In addition, damp and mould were estimated to contribute to 1 to 2 per cent of new cases of allergic rhinitis – a condition causing nasal congestion, runny nose, sneezing and itching – in that year.






